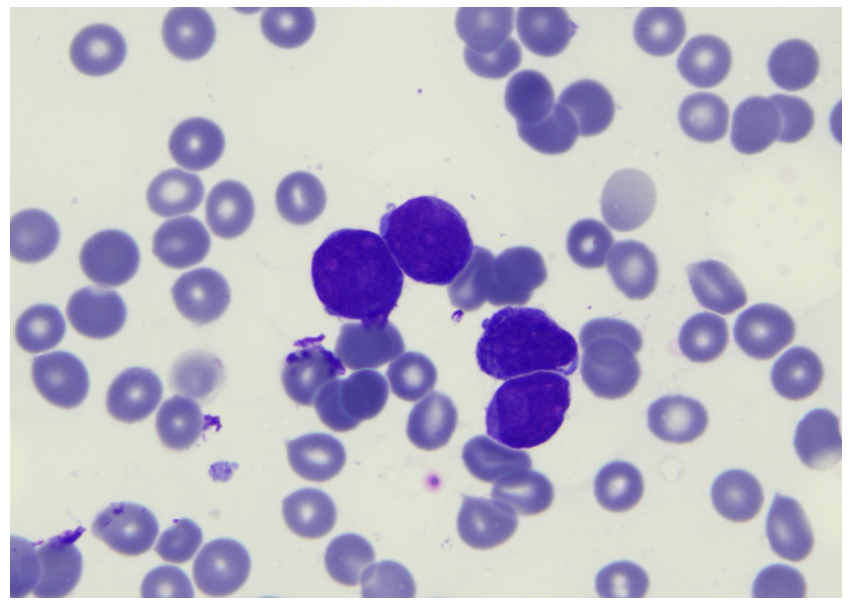

Case history
A 79-year-old male patient was admitted to the nephrology outpatient clinic with complaints of weakness, dizziness and bruising on the body for the last month. In his medical history, it was learned that he had a renal biopsy nine years ago (in 2011) due to nephrotic syndrome. In the renal biopsy; there were no findings other than mild congestion in 11 glomeruli, in immunofluorescence examination IgG-IgA-IgM-C1q-C3-C4 was negative, fibrinogen was fine, granular positive in the glomeruli, and, a diagnosis of MCD was made excluding secondary causes (Figure 1, 2). The patient responded to oral steroid treatment and was accepted in remission. In addition, there was a history of type 2 diabetes mellitus, coronary bypass surgery and benign prostatic hyperplasia. He did not describe any familial renal disease. In the physical examination; he was conscious and he was pale, his arterial blood pressure was 130/80 mmHg, heart rate 98/min and respiratory sounds were normal. The heart was tachycardic and there was a 2/6 systolic murmur in all foci. Several ecchymoses were seen on the patient's lower extremities and back, there was no organomegaly, palpable lymphadenopathy, and peripheral edema. The drugs he had been using were tamsulosin hydrochloride, isosorbide mononitrate, metoprolol, acetylsalicylic acid, metformin, olmesartan medoxomil, furosemide and escitalopram. Laboratory values on admission are shown in the table (Table 1). Ultrasonography revealed cholelithiasis, a 17 mm diameter stone and caliectatic changes in the left kidney, and simple cortical cysts in the bilateral kidneys. The size and parenchymal thickness of the kidney were reported as normal. The patient, who came for a control 7 months ago and whose hemogram values were completely normal, was consulted with hematology because of bicytopenia. Blastic cells were detected in the peripheral smear. Upon bone marrow biopsy; cellularity was 50%, increased interstitial blastic cells among marrow cells, and immunohistochemically, CD 34 (-), CD 117 (+), CD 33 (+), MPO (+), TdT (-) were detected in blastic cells (Figure 3, 4). In the genetic evaluation, monosomy 7, trisomy 8, 5q31 deletion, 7q31 deletion, 20q12 deletion and 20q13.2 deletion were not observed. With the present findings, the patient was diagnosed with acute myelocytic leukemia (M0). After the cardiological evaluation, subcutaneous azacitidine 75 mg/m2 treatment was initiated. On the 5th day of the treatment, the patient died due to cardiovascular and septic reasons.
Discussion
MN is the most common paraneoplastic glomerulonephritis when all malignancies are evaluated and it seems to be often associated with solid tumors. When it comes to hematological malignancies (especially lymphomas), the incidence of MCD increases. In addition, MN, MPGN, FSGS and Ig A nephropathy may be associated with hematological malignancies.
Minimal change disease, is a type of glomerulonephritis that presents with nephrotic syndrome (proteinuria above 3.5 g/day, hyperlipidemia/lipiduria, hypoalbuminemia and edema) and is more common in the child/adolescent period compared to adulthood (~90% vs. 10%). Glomerular immunoglobulin or complement accumulation is not observed and it is assumed that the main injury mechanism is podocytopathy. It is thought that the production of the glomerular permeability factor secondary to immune cellular dysfunction (especially immature and undifferentiated T cells (CD34 +)), and the effect of this factor on the glomerular capillaries, cause proteinuria and fusion in podocytes. There is strong evidence that this factor may be IL-13 (1). MCD can be seen secondary to drugs (NSAII, antibiotics, lithium, etc.), infections, atopic/allergic conditions, and in the course of other glomerular diseases (IgA nephropathy, lupus nephritis). It can also be seen as paraneoplastic in the course of hematological malignancies (Hodgkin lymphoma, non-Hodgkin lymphoma, leukemias), and solid organ tumors (thymoma, renal cell carcinoma, mesothelioma), especially in middle and advanced ages. Hodgkin lymphoma-MCD association is one of the best described examples of paraneoplastic glomerulonephritis. In the most comprehensive study examining this association, 21 patients participated. In this multicenter study of French origin, MCD was detected in 8 of 21 patients before the diagnosis of lymphoma, additionally the mean time between MCD-Hodgkin lymphoma in these patients was 28.8 months, and the longest was 10 years (2).
Acute myeloid leukemia is a clinical condition that occurs as a result of clonal proliferation of myeloid precursor cells. It may be presented with varying degrees of cytopenia’s, due to leukemic blast deposits in peripheral blood, bone marrow and other organs. Furthermore, it constitutes 80% of acute leukemias in adults, and the average age at diagnosis is approximately 65. Renal involvement in the course of AML usually includes tumor lysis syndrome or acute kidney injury (prerenal injury, drug/antibiotic associated renal damage). As in other hematological and solid organ tumors, paraneoplastic glomerulonephritis can be seen simultaneously before or after AML diagnosis. Cancer can be clinically diagnosed years after the detection of renal disease in paraneoplastic glomerulonephritis. Therefore, some authors recommend routine, periodic screening (every 5 years under 50 to 60 years of age, and every 3 years if older) in late-onset types of glomerulonephritis, due to the lack of clear guidelines on this subject (3).
In the study conducted by Bjørneklett et al., it was shown that there could be patients who could be diagnosed with cancer up to 157 months after MN was detected. In this study, it was shown that the probability of renal biopsy-cancer detection increased statistically and significantly (standardized incidence ratio of 2.30) in the following 5 to 15 years period, as in the first 5 years after renal biopsy. It has been shown that the increased risk of cancer is not limited only to the short term immediately after the diagnosis of renal disease, but that this risk continues for many years after the renal disease diagnosis (4).
The pathophysiological relation between MCD and cancer is not as clear as the relation between MN and cancer. The most obvious mechanism to blame is VEGF-related. It is stated that the glomerular effect of anti-VEGF agents is TMA (with endothelial damage) or MCD/FSGS (with podocytopathic effect). These immunohistological effects are similar to HIV associated nephropathy (loss of certain podocytes differentiation markers and proliferation of glomerular epithelial cells as indicated by KI-67 staining). In particular, it is emphasized that podocytopathy secondary to tyrosine kinase inhibitors occurs. In this study in which the renal effects of anti VEGF agents were monitored, it was observed that histochemically, Wnt-1 expression was decreased, c-mip accumulation, absence of synaptopodin in podocytes and KI-67 staining, were significantly higher in the group with MCN/cFSGS-like lesions. The reduced presence of VEGF in the glomeruli may have deleterious effects on kidney function since the glomerular filtration barrier may be particularly susceptible to toxicity from VEGF inhibitors (5). Taniguchi et al. presented a case with coexistence of rectal adenocarcinoma and MCD. In this case, it was shown that the preoperative plasma VEGF level (1,880 pg/ml) significantly decreased (52.3 pg/ml) 3 months after the primary cancer was resected (6).
The association of AML-nephrotic syndrome is relatively less defined in the literature compared to other hematological malignancies (CLL, Hodgkin lymphoma, non-Hodgkin lymphoma). Chahal et al. reported graft versus host disease-associated MCD in a patient who had a stem cell transplant for AML at 18 months (7). AML associated with membranous nephropathy was reported by Sahiner et al., in this case, 3 months after the diagnosis of membranous nephropathy, the patient was clinically diagnosed with AML (8).
An interesting point in our case was the diagnosis of AML as long as 9 years after the diagnosis of MCD and when the renal disease was already in remission. This time-in terms of the coexistence of these two clinical conditions has been evaluated as the longest period that can be detected in literature. Was this just a coincidence? In our opinion, considering the association of hematological malignancies with nephrotic syndromes, it does not seem like a coincidence. It should be kept in mind that in geriatric patients with diagnoses such as MCD and MN, any cytopenia during follow-up should be considered, and it is thought that it may be an indicator of an underlying hematological malignancy. It seems rational to perform this follow-up not only during the diagnosis of glomerulonephritis but also periodically in the long term; especially in clinical situations such as MCD that occur in geriatric patients, this approach becomes even more important.